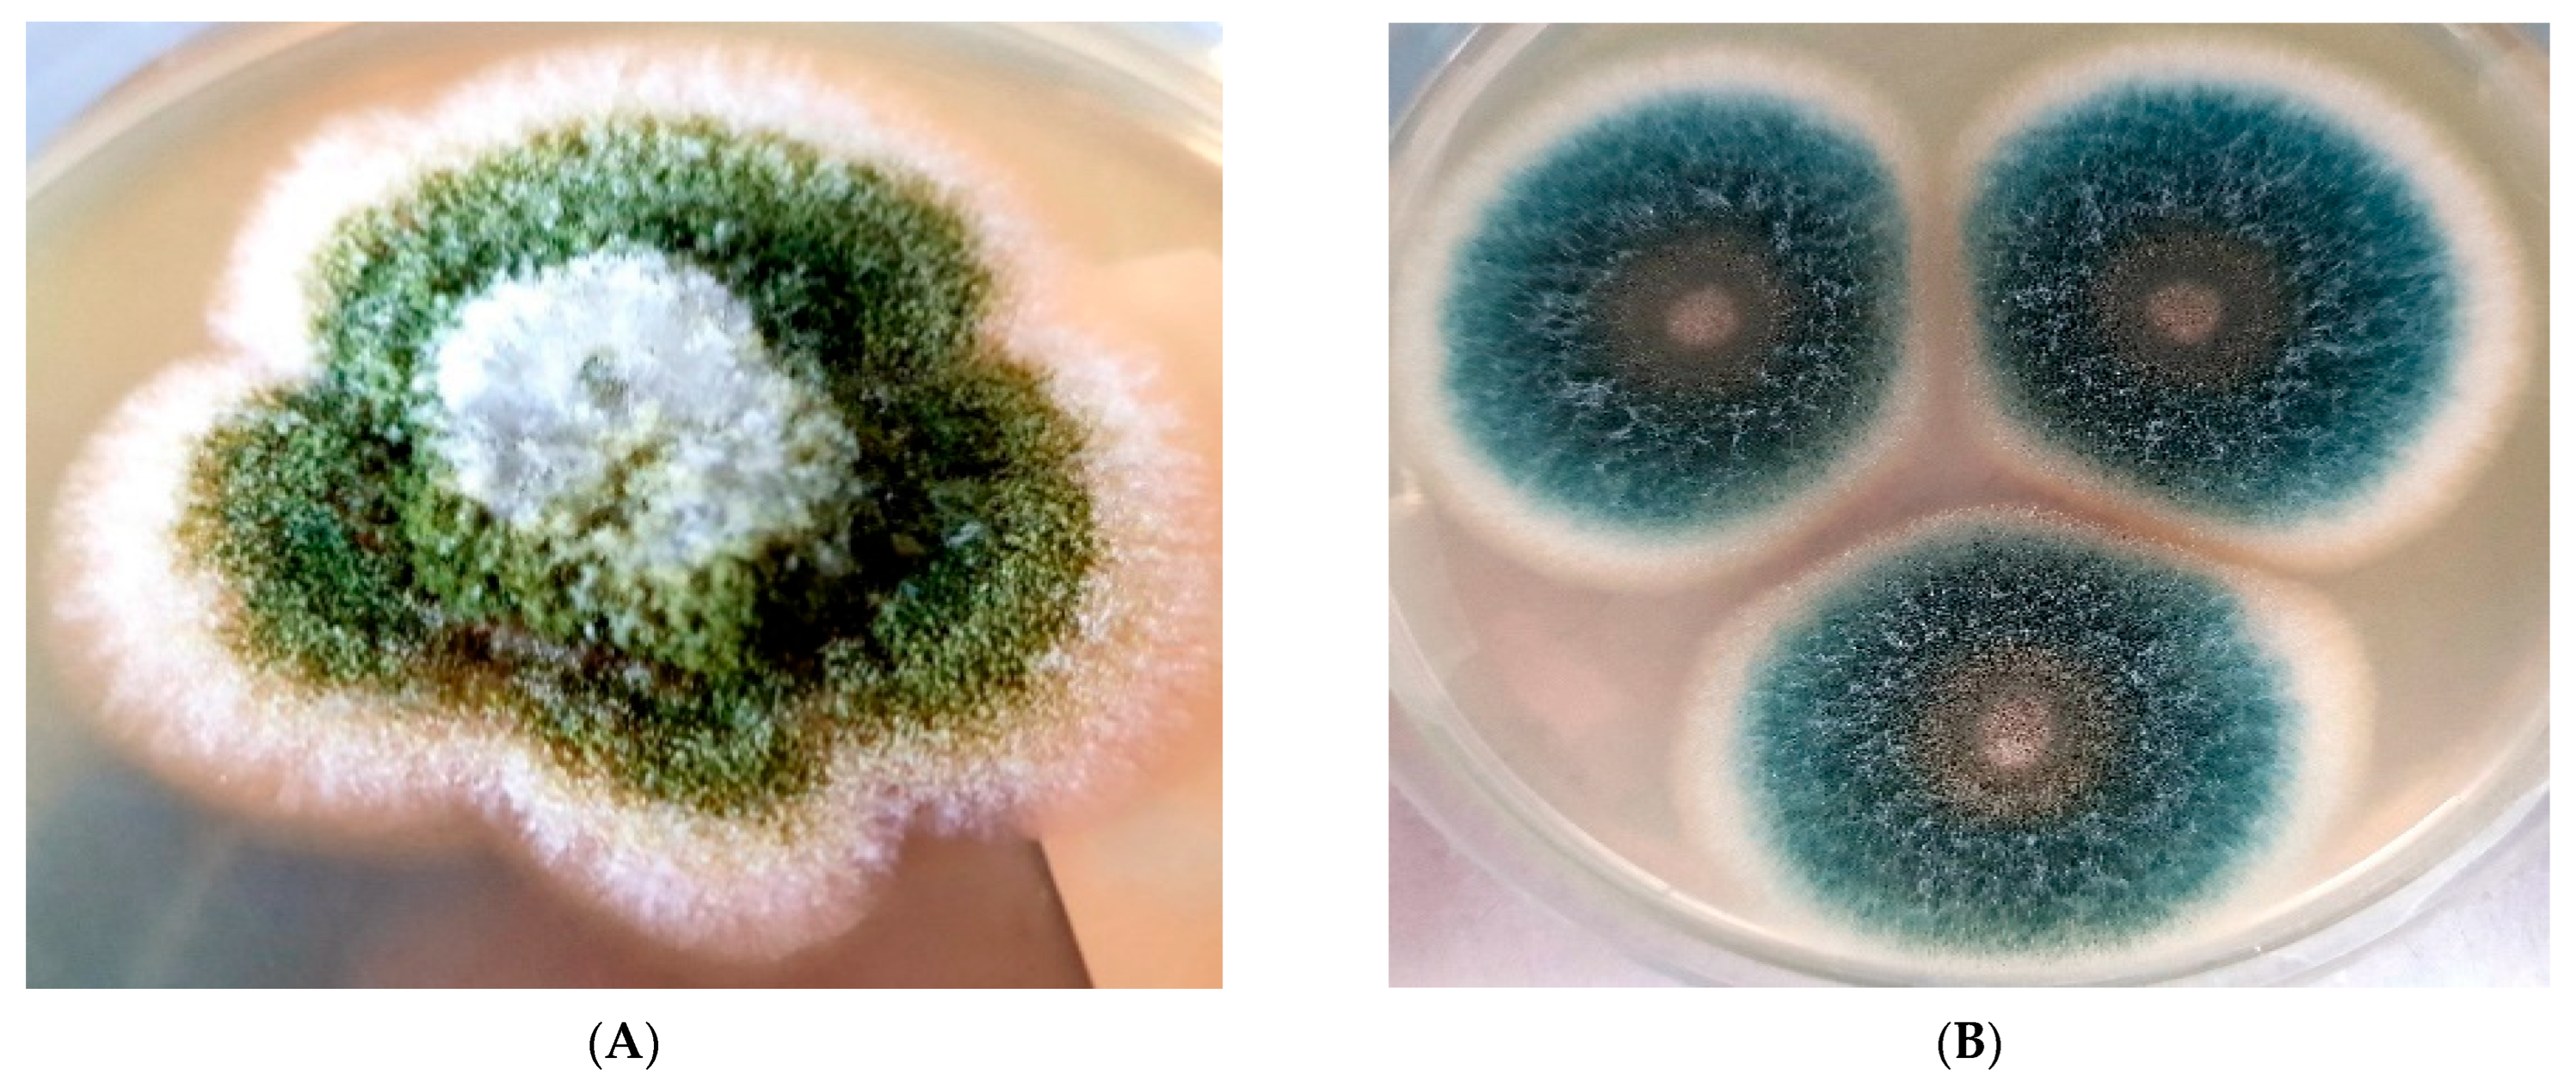

Azole Resistance in Aspergillus Species Isolated from Clinical Samples: A Nine-Year Single-Center Study in Turkey (2015–2023)
Abstract
1. Introduction
2. Methods
2.1. Clinical Isolates
2.2. Antifungal Susceptibility Tests
- Itraconazole: Susceptible (S): ≤1 mg/L; Resistant (R): >1 mg/L;
- Voriconazole: Susceptible (S): ≤1 mg/L; Resistant (R): >1 mg/L;
- Posaconazole: Susceptible (S): ≤0.25 mg/L; Resistant (R): >0.25 mg/L.
3. Results
3.1. Distribution of Isolates
3.2. Antifungal Susceptibility Patterns
4. Discussion
5. Conclusions
Author Contributions
Funding
Data Availability Statement
Conflicts of Interest
Correction Statement
Ethical Approval
References
- Martins-Santana, L.; Rezende, C.P.; Rossi, A.; Martinez-Rossi, N.M.; Almeida, F. Addressing Microbial Resistance Worldwide: Challenges over Controlling Life-Threatening Fungal Infections. Pathogens 2023, 12, 293. [Google Scholar] [CrossRef]
- Denning, D.W. Global incidence and mortality of severe fungal disease. Lancet Infect. Dis. 2024, 24, e428–e438. [Google Scholar] [CrossRef] [PubMed]
- Gaffney, S.; Kelly, D.M.; Rameli, P.M.; Kelleher, E.; Martin-Loeches, I. Invasive pulmonary aspergillosis in the intensive care unit: Current challenges and best practices. APMIS 2023, 131, 654–667. [Google Scholar] [CrossRef]
- WHO. WHO Fungal Priority Pathogens List to Guide Research, Development and Public Health Action; World Health Organization: Geneva, Switzerland, 2022. [Google Scholar]
- Garnacho-Montero, J.; Barrero-García, I.; León-Moya, C. Fungal infections in immunocompromised critically ill patients. J. Intensive Med. 2024, 4, 299–306. [Google Scholar] [CrossRef]
- Wang, Y.; Zhang, L.; Zhou, L.; Zhang, M.; Xu, Y. Epidemiology, Drug Susceptibility, and Clinical Risk Factors in Patients with Invasive Aspergillosis. Front. Public Health 2022, 10, 835092. [Google Scholar] [CrossRef] [PubMed]
- Lin, S.J.; Schranz, J.; Teutsch, S.M. Aspergillosis case-fatality rate: Systematic review of the literature. Clin. Infect. Dis. 2001, 32, 358–366. [Google Scholar] [CrossRef]
- Kanaujia, R.; Singh, S.; Rudramurthy, S.M. Aspergillosis: An Update on Clinical Spectrum, Diagnostic Schemes, and Management. Curr. Fungal Infect. Rep. 2023, 17, 144–155. [Google Scholar] [CrossRef] [PubMed]
- Meis, J.F.; Chowdhary, A.; Rhodes, J.L.; Fisher, M.C.; Verweij, P.E. Clinical implications of globally emerging azole resistance in Aspergillus fumigatus. Philos. Trans. R. Soc. B 2016, 371, 20150460. [Google Scholar] [CrossRef]
- Boyer, J.; Feys, S.; Zsifkovits, I.; Hoenigl, M.; Egger, M. Treatment of Invasive Aspergillosis: How It’s Going, Where It’s Heading. Mycopathologia 2023, 188, 667–681. [Google Scholar] [CrossRef]
- Wang, J.; Sun, J.; Yang, D.W.; Wang, H.S.; Meng, W.; Li, H.Y. Appraisal of guidelines and variations in recommendations on drug therapy for invasive aspergillosis prevention and treatment. Front. Pharmacol. 2025, 16, 1443487. [Google Scholar] [CrossRef]
- Rosam, K.; Monk, B.C.; Lackner, M. Sterol 14α-Demethylase Ligand-Binding Pocket-Mediated Acquired and Intrinsic Azole Resistance in Fungal Pathogens. J. Fungi 2021, 7, 1. [Google Scholar] [CrossRef]
- Bosetti, D.; Neofytos, D. Invasive Aspergillosis and the Impact of Azole-resistance. Curr. Fungal Infect. Rep. 2023, 17, 77–86. [Google Scholar] [CrossRef] [PubMed]
- Pérez-Cantero, A.; López-Fernández, L.; Guarro, J.; Capilla, J. Azole resistance mechanisms in Aspergillus: Update and recent advances. Int. J. Antimicrob. Agents 2020, 55, 105807. [Google Scholar] [CrossRef]
- Fisher, M.C.; Alastruey-Izquierdo, A.; Berman, J.; Bicanic, T.; Bignell, E.M.; Bowyer, P.; Bromley, M.; Brüggemann, R.; Garber, G.; Cornely, O.A.; et al. Tackling the emerging threat of antifungal resistance to human health. Nat. Rev. Microbiol. 2022, 20, 557–571. [Google Scholar] [CrossRef]
- Jørgensen, L.N.; Heick, T.M. Azole Use in Agriculture, Horticulture, and Wood Preservation—Is It Indispensable? Front. Cell. Infect. Microbiol. 2021, 11, 730297. [Google Scholar] [CrossRef]
- Debergh, H.; Castelain, P.; Goens, K.; Lefevere, P.; Claessens, J.; De Vits, E.; Vissers, M.; Blindeman, L.; Bataille, C.; Saegerman, C.; et al. Detection of pan-azole resistant Aspergillus fumigatus in horticulture and a composting facility in Belgium. Med. Mycol. 2024, 62, myae055. [Google Scholar] [CrossRef]
- Tashiro, M.; Nakano, Y.; Shirahige, T.; Kakiuchi, S.; Fujita, A.; Tanaka, T.; Takazono, T.; Izumikawa, K. Comprehensive Review of Environmental Surveillance for Azole-Resistant Aspergillus fumigatus: A Practical Roadmap for Hospital Clinicians and Infection Control Teams. J. Fungi 2025, 11, 96. [Google Scholar] [CrossRef]
- Ener, B.; Ergin, Ç.; Gülmez, D.; Ağca, H.; Tikveşli, M.; Aksoy, S.A.; Otkun, M.; Siğ, A.K.; Öğünç, D.; Özhak, B.; et al. Frequency of azole resistance in clinical and environmental strains of Aspergillus fumigatus in Turkey: A multicentre study. J. Antimicrob. Chemother. 2022, 77, 1894–1898. [Google Scholar] [CrossRef] [PubMed]
- Özmerdiven, G.E.; Ak, S.; Ener, B.; Ağca, H.; Cilo, B.D.; Tunca, B.; Akalın, H. First determination of azole resistance in Aspergillus fumigatus strains carrying the T.R.34/L98H mutations in Turkey. J. Infect. Chemother. 2015, 21, 581–586. [Google Scholar] [CrossRef] [PubMed]
- Westblade, L.F.; Burd, E.M.; Lockhart, S.R.; Procop, G.W. Larone’s Medically Important Fungi: A Guide to Identification; John Wiley & Sons: Hoboken, NJ, USA, 2023. [Google Scholar]
- Kidd, S.; Halliday, C.; Ellis, D. Descriptions of Medical Fungi; CABI: Oxfordshire, UK, 2022. [Google Scholar]
- Rozaliyani, A.; Abdullah, A.; Setianingrum, F.; Sjamsuridzal, W.; Wahyuningsih, R.; Bowolaksono, A.; Fatril, A.E.; Adawiyah, R.; Tugiran, M.; Syam, R.; et al. Unravelling the Molecular Identification and Antifungal Susceptibility Profiles of Aspergillus spp. Isolated from Chronic Pulmonary Aspergillosis Patients in Jakarta, Indonesia: The Emergence of Cryptic Species. J. Fungi 2022, 8, 411. [Google Scholar] [CrossRef] [PubMed]
- Tümbay, E. Tıbbi Mikoloji 1. Baskı; Gılead: İzmir, Turkey, 2021. [Google Scholar]
- Patterson, T.F.; Thompson, G.R.; Denning, D.W.; Fishman, J.A.; Hadley, S.; Herbrecht, R.; Kontoyiannis, D.P.; Marr, K.A.; Morrison, V.A.; Nguyen, M.H.; et al. Practice Guidelines for the Diagnosis and Management of Aspergillosis: 2016 Update by the Infectious Diseases Society of America. Clin. Infect. Dis. 2016, 63, e1–e60. [Google Scholar] [CrossRef]
- The European Committee on Antimicrobial Susceptibility Testing. Overview of Antifungal ECOFFs and Clinical Breakpoints for Yeasts, Moulds and Dermatophytes Using the EUCAST E.Def 7.3, E.Def 9.4 and E.Def 11.0 Procedures. Version 3. 2022. Available online: http://www.eucast.org (accessed on 6 September 2023).
- The European Committee on Antimicrobial Susceptibility Testing. Breakpoint Tables for Interpretation of MICs for Antifungal Agents, Version 11.0. 2024. Available online: http://www.eucast.org/astoffungi/clinicalbreakpointsforantifungals/ (accessed on 6 September 2023).
- Pfaller, M.A.; Carvalhaes, C.G.; Rhomberg, P.; Messer, S.A.; Castanheira, M. Antifungal susceptibilities of opportunistic filamentous fungal pathogens from the Asia and Western Pacific Region: Data from the SENTRY Antifungal Surveillance Program (2011–2019). J. Antibiot. 2021, 74, 519–527. [Google Scholar] [CrossRef]
- Nargesi, S.; Valadan, R.; Abastabar, M.; Kaboli, S.; Thekkiniath, J.; Hedayati, M.T. A Whole Genome Sequencing-Based Approach to Track down Genomic Variants in Itraconazole-Resistant Species of Aspergillus from Iran. J. Fungi 2022, 8, 1091. [Google Scholar] [CrossRef]
- Mortensen, K.L.; Jensen, R.H.; Johansen, H.K.; Skov, M.; Pressler, T.; Howard, S.J.; Leatherbarrow, H.; Mellado, E.; Arendrup, M.C. Aspergillus species and other molds in respiratory samples from patients with cystic fibrosis: A laboratory-based study with focus on Aspergillus fumigatus azole resistance. J. Clin. Microbiol. 2011, 49, 2243–2251. [Google Scholar] [CrossRef]
- Morio, F.; Aubin, G.G.; Danner-Boucher, I.; Haloun, A.; Sacchetto, E.; Garcia-Hermoso, D.; Bretagne, S.; Miegeville, M.; Le Pape, P. High prevalence of triazole resistance in Aspergillus fumigatus, especially mediated by TR/L98H, in a French cohort of patients with cystic fibrosis. J. Antimicrob. Chemother. 2012, 67, 1870–1873. [Google Scholar] [CrossRef]
- Burgel, P.R.; Baixench, M.T.; Amsellem, M.; Audureau, E.; Chapron, J.; Kanaan, R.; Honoré, I.; Dupouy-Camet, J.; Dusser, D.; Klaassen, C.H.; et al. High prevalence of azole-resistant Aspergillus fumigatus in adults with cystic fibrosis exposed to itraconazole. Antimicrob. Agents Chemother. 2012, 56, 869–874. [Google Scholar] [CrossRef] [PubMed]
- Singh, A.; Sharma, B.; Mahto, K.K.; Meis, J.F.; Chowdhary, A. High-Frequency Direct Detection of Triazole Resistance in Aspergillus fumigatus from Patients with Chronic Pulmonary Fungal Diseases in India. J. Fungi 2020, 6, 67. [Google Scholar] [CrossRef] [PubMed]
- Rhodes, J.; Abdolrasouli, A.; Dunne, K.; Sewell, T.R.; Zhang, Y.; Ballard, E.; Brackin, A.P.; van Rhijn, N.; Chown, H.; Tsitsopoulou, A.; et al. Population genomics confirms acquisition of drug-resistant Aspergillus fumigatus infection by humans from the environment. Nat. Microbiol. 2022, 7, 663–674. [Google Scholar] [CrossRef] [PubMed]
- Guegan, H.; Prat, E.; Robert-Gangneux, F.; Gangneux, J.P. Azole Resistance in Aspergillus fumigatus: A Five-Year Follow Up Experience in a Tertiary Hospital with a Special Focus on Cystic Fibrosis. Front. Cell. Infect. Microbiol. 2021, 10, 613774. [Google Scholar] [CrossRef]
- Van Der Linden, J.W.M.; Arendrup, M.C.; Melchers, W.J.G.; Verweij, P.E. Azole Resistance of Aspergillus fumigatus in ımmunocompromised patients with ınvasive aspergillosis. Emerg. Infect. Dis. 2016, 22, 158–159. [Google Scholar] [CrossRef]
- Fischer, J.; van Koningsbruggen-Rietschel, S.; Rietschel, E.; Vehreschild, M.J.G.T.; Wisplinghoff, H.; Kronke, M.; Hamprecht, A. Prevalence and molecular characterization of azole resistance in Aspergillus spp. isolates from German cystic fibrosis patients. J. Antimicrob. Chemother. 2014, 69, 1533–1536. [Google Scholar] [CrossRef]
- Prigitano, A.; Esposto, M.C.; Grancini, A.; Biffi, A.; Innocenti, P.; Cavanna, C.; Lallitto, F.; Mollaschi, E.M.G.; Bandettini, R.; Oltolini, C.; et al. Azole resistance in Aspergillus isolates by different types of patients and correlation with environment—An Italian prospective multicentre study (ARiA study). Mycoses 2021, 64, 528–536. [Google Scholar] [CrossRef] [PubMed]
- Rivero-Menendez, O.; Alastruey-Izquierdo, A.; Mellado, E.; Cuenca-Estrella, M. Triazole resistance in Aspergillus spp.: A worldwide problem? J. Fungi 2016, 2, 21. [Google Scholar] [CrossRef] [PubMed]
- Bueid, A.; Howard, S.J.; Moore, C.B.; Richardson, M.D.; Harrison, E.; Bowyer, P.; Denning, D.W. Azole antifungal resistance in Aspergillus fumigatus: 2008 and 2009. J. Antimicrob. Chemother. 2010, 65, 2116–2118. [Google Scholar] [CrossRef]
- Araujo, R.; Pina-Vaz, C.; Rodrigues, A.G.; Amorim, A.; Gusmao, L. Simple and highly discriminatory microsatellite-based multiplex PCR for Aspergillus fumigatus strain typing. Clin. Microbiol. Infect. 2009, 15, 260–266. [Google Scholar] [CrossRef]
- Balajee, S.A.; Gribskov, J.; Brandt, M.; Ito, J.; Fothergill, A.; Marr, K.A. Mistaken identity: Neosartorya pseudofisheri and its anamorph masquerading as Aspergillus fumigatus. J. Clin. Microbiol. 2005, 43, 5996–5999. [Google Scholar] [CrossRef]
- Nagano, Y.; Elborn, J.S.; Millar, B.C. Comparison of techniques to examine the diversity of fungi in adult patients with cystic fibrosis. Med. Mycol. 2010, 48, 166–176. [Google Scholar] [CrossRef]
- Chryssanthou, E. In Vitro Susceptibility of Respiratory Isolates of Aspergillus species to Itraconazole and Amphotericin B. Acquired Resistance to Itraconazole. Scand. J. Infect. Dis. 1997, 29, 509–512. [Google Scholar] [CrossRef]
- Verweij, P.E.; Chowdhary, A.; Melchers, W.J.G.; Meis, J.F.; Weinstein, R.A. Azole resistance in Aspergillus fumigatus: Can we retain the clinical use of mold-active antifungal azoles? Clin. Infect. Dis. 2016, 62, 362–368. [Google Scholar] [CrossRef] [PubMed]
- Duong, T.N.; Le, T.V.; Tran, K.H.; Nguyen, P.T.; Nguyen, B.T.; Nguyen, T.A.; Nguyen, H.-L.P.; Nguyen, B.-N.T.; Fisher, M.C.; Rhodes, J. Azole-resistant Aspergillus fumigatus is highly prevalent in the environment of Vietnam, with marked variability by land use type. Environ. Microbiol. 2021, 23, 7632–7642. [Google Scholar] [CrossRef]
- Pfaller, M.A.; Carvalhaes, C.G.; Rhomberg, P.R.; Desphande, L.M.; Castanheira, M. Trends in the activity of mold-active azole agents against Aspergillus fumigatus clinical isolates with and without cyp51 alterations from Europe and North America (2017–2021). J. Clin. Microbiol. 2024, 62, e0114123. [Google Scholar] [CrossRef] [PubMed]
- van der Linden, J.W.; Snelders, E.; Kampinga, G.A.; Rijnders, B.J.; Mattsson, E.; Debets-Ossenkopp, Y.J.; Kuijper, E.J.; Van Tiel, F.H.; Melchers, W.J.; Verweij, P.E. Clinical implications of azole resistance in Aspergillus fumigatus, the Netherlands, 2007–2009. Emerg. Infect. Dis. 2011, 17, 1846–1854. [Google Scholar] [CrossRef] [PubMed]
- Van Der Linden, J.; Arendrup, M.; Warris, A.; Lagrou, K.; Pelloux, H.; Hauser, P.; Chryssanthou, E.; Mellado, E.; Kidd, S.E.; Tortorano, A.M.; et al. Prospective multicenter international surveillance of azole resistance in Aspergillus fumigatus. Emerg. Infect. Dis. 2015, 21, 1041–1044. [Google Scholar] [CrossRef] [PubMed]
- Vermeulen, E.; Maertens, J.; Schoemans, H.; Lagrou, K. Azole-resistant Aspergillus fumigatus due to TR46/Y121F/T289A mutation emerging in Belgium. Euro. Surveill. 2012, 17, 20326. [Google Scholar] [CrossRef]
- Van Der Linden, J.W.; Camps, S.M.; Kampinga, G.A.; Arends, J.P.; Debets-Ossenkopp, Y.J.; Haas, P.J.; Rijnders, B.J.; Kuijper, E.J.; van Tiel, F.H.; Varga, J.; et al. Aspergillosis due to voriconazole highly resistant Aspergillus fumigatus and recovery of genetically related resistant isolates from domiciles. Clin. Infect. Dis. 2013, 57, 513–520. [Google Scholar] [CrossRef]
- Zeng, M.; Zhou, X.; Yang, C.; Liu, Y.; Zhang, J.; Xin, C.; Qin, G.; Liu, F.; Song, Z. Comparative analysis of the biological characteristics and mechanisms of azole resistance of clinical Aspergillus fumigatus strains. Front. Microbiol. 2023, 14, 1253197. [Google Scholar] [CrossRef] [PubMed]
- Lelièvre, L.; Groh, M.; Angebault, C.; Maherault, A.-C.; Didier, E.; Bougnoux, M.-E. Azole resistant Aspergillus fumigatus: An emerging problem. Med. Mal. Infect. 2013, 43, 139–145. [Google Scholar] [CrossRef]
- Pfaller, J.B.; Messer, S.A.; Hollis, R.J.; Diekema, D.J.; Pfaller, M.A. In vitro susceptibility testing of Aspergillus spp.: Comparison of E-test and reference microdilution methods for determining voriconazole and itraconazole MICs. J. Clin. Microbiol. 2003, 41, 1126–1129. [Google Scholar] [CrossRef] [PubMed]
- Dellière, S.; Verdurme, L.; Bigot, J.; Dannaoui, E.; Senghor, Y.; Botterel, F.; Fekkar, A.; Bougnoux, M.E.; Hennequin, C.; Guitard, J. Comparison of the MICs Obtained by Gradient Concentration Strip and EUCAST Methods for Four Azole Drugs and Amphotericin B against Azole-Susceptible and -Resistant Aspergillus Section Fumigati Clinical Isolates. Antimicrob. Agents Chemother. 2020, 64, e01597-19. [Google Scholar] [CrossRef] [PubMed]
- Idelevich, E.A.; Groß, U.; Becker, K.; Bader, O. Comparative evaluation of different gradient diffusion tests for detection of azole resistance in Aspergillus fumigatus. Diagn. Microbiol. Infect. Dis. 2018, 91, 52–54. [Google Scholar] [CrossRef]
- Lamoth, F.; Alexander, B.D. Comparing Etest and Broth Microdilution for Antifungal Susceptibility Testing of the Most-Relevant Pathogenic Molds. J. Clin. Microbiol. 2015, 53, 3176–3181. [Google Scholar] [CrossRef]
- Tan, X.T.; Mokhtar, N.N.B.; Hii, S.Y.F.; Amran, F. Antifungal Susceptibility and Genotypic Analysis of cyp51A Mutations in Aspergillus fumigatus Isolates in Malaysia. Infect. Drug Resist. 2024, 17, 2159–2168. [Google Scholar] [CrossRef] [PubMed]
- Resendiz Sharpe, A.; Lagrou, K.; Meis, J.F.; Chowdhary, A.; Lockhart, S.R.; Verweij, P.E. Triazole resistance surveillance in Aspergillus fumigatus. Med. Mycol. 2018, 56 (Suppl. 1), 83–92. [Google Scholar] [CrossRef] [PubMed]

| Clinical Isolates | TISSUE | ABSCESS | RESPIRATORY | OTHER | TOTAL | |||||||
|---|---|---|---|---|---|---|---|---|---|---|---|---|
| Tissue | Abscess | Cornea Abscess | BAL | Sputum | ETA | Nasal Sinus Content | CSF | Joint Fluid | Catheter | Pleura | ||
| A. fumigatus | 11 | 16 | 1 | 24 | 20 | 10 | — | 2 | 2 | 3 | 1 | 90 |
| A. flavus | 13 | 3 | 4 | 12 | 10 | 1 | 2 | — | — | — | 1 | 46 |
| Aspergillus spp. | 11 | 8 | 3 | 9 | 10 | 2 | — | — | — | — | — | 43 |
| A. pseudoglaucus | 1 | — | 1 | — | — | — | — | — | — | — | — | 2 |
| A. terreus | — | 2 | — | 3 | 4 | — | — | — | 1 | — | — | 10 |
| A. niger | 2 | — | — | 4 | 3 | — | — | — | — | — | — | 9 |
| Anti Fungal | No (n=) | ≤0.002 | 0.003 | 0.004 | 0.008 | 0.012 | 0.016 | 0.023 | 0.032 | 0.047 | 0.064 | 0.094 | 0.125 | 0.19 | 0.25 | 0.38 | 0.50 | 0.75 | 1.0 | 1.5 | 4 | >32 |
|---|---|---|---|---|---|---|---|---|---|---|---|---|---|---|---|---|---|---|---|---|---|---|
| VOR | 88 | — | — | — | — | — | — | — | 2 | — | 1 | 6 | 23 | 17 | 32 | 4 | 2 | — | — | — | — | 1 |
| ITR | 84 | — | — | — | — | — | — | — | — | — | — | — | — | 4 | 5 | 24 | 16 | 12 | 13 | 9 | 1 | — |
| POS | 87 | 7 | 6 | 4 | 2 | 4 | 1 | 2 | 3 | 11 | 5 | 13 | 13 | 10 | 4 | 1 | — | 1 | — | — | — | — |
| Anti Fungal | No (n=) | ≤0.002 | 0.012 | 0.016 | 0.023 | 0.032 | 0.047 | 0.064 | 0.094 | 0.125 | 0.19 | 0.25 | 0.38 | 0.50 | 0.75 | 1.0 |
|---|---|---|---|---|---|---|---|---|---|---|---|---|---|---|---|---|
| VOR | 46 | — | — | — | — | — | 2 | 4 | 6 | 9 | 9 | 6 | 7 | 2 | 1 | — |
| ITR | 46 | — | — | — | — | — | — | 1 | — | 3 | 5 | 5 | 15 | 12 | 2 | 3 |
| POS | 46 | 4 | 1 | 3 | 2 | 4 | 7 | 9 | 5 | 7 | 4 | — | — | — | — | — |
Disclaimer/Publisher’s Note: The statements, opinions and data contained in all publications are solely those of the individual author(s) and contributor(s) and not of MDPI and/or the editor(s). MDPI and/or the editor(s) disclaim responsibility for any injury to people or property resulting from any ideas, methods, instructions or products referred to in the content. |
© 2025 by the authors. Licensee MDPI, Basel, Switzerland. This article is an open access article distributed under the terms and conditions of the Creative Commons Attribution (CC BY) license (https://creativecommons.org/licenses/by/4.0/).
Share and Cite
Yazgan, Z.; Çalışkan, R.; Aygün, G. Azole Resistance in Aspergillus Species Isolated from Clinical Samples: A Nine-Year Single-Center Study in Turkey (2015–2023). J. Fungi 2025, 11, 659. https://doi.org/10.3390/jof11090659
Yazgan Z, Çalışkan R, Aygün G. Azole Resistance in Aspergillus Species Isolated from Clinical Samples: A Nine-Year Single-Center Study in Turkey (2015–2023). Journal of Fungi. 2025; 11(9):659. https://doi.org/10.3390/jof11090659
Chicago/Turabian StyleYazgan, Zeynep, Reyhan Çalışkan, and Gökhan Aygün. 2025. "Azole Resistance in Aspergillus Species Isolated from Clinical Samples: A Nine-Year Single-Center Study in Turkey (2015–2023)" Journal of Fungi 11, no. 9: 659. https://doi.org/10.3390/jof11090659
APA StyleYazgan, Z., Çalışkan, R., & Aygün, G. (2025). Azole Resistance in Aspergillus Species Isolated from Clinical Samples: A Nine-Year Single-Center Study in Turkey (2015–2023). Journal of Fungi, 11(9), 659. https://doi.org/10.3390/jof11090659

